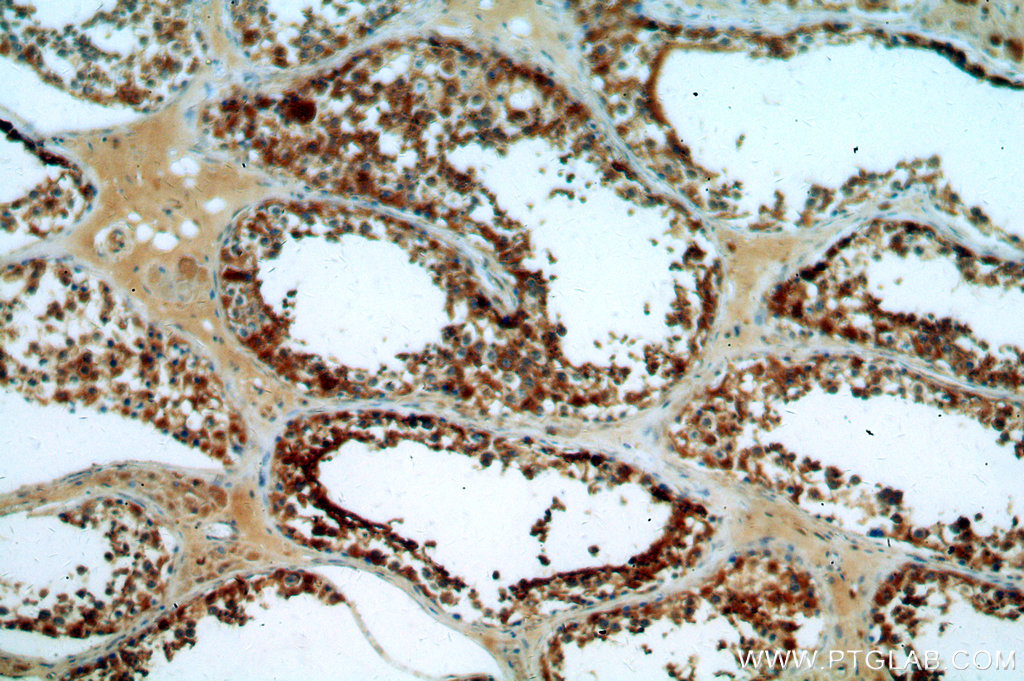

验证数据展示
经过测试的应用
| Positive WB detected in | HEK-293 cells, A431 cells, HeLa cells, MDA-MB-231 cells, mouse testis tissue, rat kidney tissue, Jurkat cells, NIH/3T3 cells, MCF-7 cells |
| Positive IP detected in | mouse kidney tissue |
| Positive IHC detected in | human heart tissue, human skeletal muscle tissue, human testis tissue Note: suggested antigen retrieval with TE buffer pH 9.0; (*) Alternatively, antigen retrieval may be performed with citrate buffer pH 6.0 |
| Positive IF/ICC detected in | HepG2 cells |
| Positive FC (Intra) detected in | HepG2 cells |
推荐稀释比
| 应用 | 推荐稀释比 |
|---|---|
| Western Blot (WB) | WB : 1:2000-1:10000 |
| Immunoprecipitation (IP) | IP : 0.5-4.0 ug for 1.0-3.0 mg of total protein lysate |
| Immunohistochemistry (IHC) | IHC : 1:20-1:200 |
| Immunofluorescence (IF)/ICC | IF/ICC : 1:50-1:500 |
| Flow Cytometry (FC) (INTRA) | FC (INTRA) : 0.25 ug per 10^6 cells in a 100 µl suspension |
| It is recommended that this reagent should be titrated in each testing system to obtain optimal results. | |
| Sample-dependent, Check data in validation data gallery. | |
产品信息
19987-1-AP targets LDHA-Specific in WB, IHC, IF/ICC, FC (Intra), IP, CoIP, RIP, ELISA applications and shows reactivity with human, mouse, rat samples.
| 经测试应用 | WB, IHC, IF/ICC, FC (Intra), IP, ELISA Application Description |
| 文献引用应用 | WB, IHC, IF, IP, CoIP, RIP |
| 经测试反应性 | human, mouse, rat |
| 文献引用反应性 | human, mouse, rat, rabbit, chicken, goat |
| 免疫原 |
Peptide 种属同源性预测 |
| 宿主/亚型 | Rabbit / IgG |
| 抗体类别 | Polyclonal |
| 产品类型 | Antibody |
| 全称 | lactate dehydrogenase A |
| 别名 | LDHA, Cell proliferation-inducing gene 19 protein, EC:1.1.1.27, lactate dehydrogenase A, LDH A |
| 计算分子量 | 37 kDa |
| 观测分子量 | 32-37 kDa |
| GenBank蛋白编号 | NM_005566 |
| 基因名称 | LDHA |
| Gene ID (NCBI) | 3939 |
| RRID | AB_10646429 |
| 偶联类型 | Unconjugated |
| 形式 | Liquid |
| 纯化方式 | Antigen affinity purification |
| UNIPROT ID | P00338 |
| 储存缓冲液 | PBS with 0.02% sodium azide and 50% glycerol, pH 7.3. |
| 储存条件 | Store at -20°C. Stable for one year after shipment. Aliquoting is unnecessary for -20oC storage. |
背景介绍
Lactate dehydrogenase (LDH) is composed of A subunits predominate in skeletal muscle and B subunits are abundantly produced in brain and heart. The LDHA (lactate dehydrogenase A) and COPB1 (coatomer protein complex, subunit beta 1)genes, are involved in energy metabolism and protein transport processes. Both genes might play important roles in muscle development. It has some isoforms with the molecular mass of 27-40 kDa and can form a homotetramer(PMID:11276087). This antibody is specific to LDHA and has no cross reaction to LDHB and LDHC.
实验方案
| Product Specific Protocols | |
|---|---|
| FC protocol for LDHA-Specific antibody 19987-1-AP | Download protocol |
| IF protocol for LDHA-Specific antibody 19987-1-AP | Download protocol |
| IHC protocol for LDHA-Specific antibody 19987-1-AP | Download protocol |
| IP protocol for LDHA-Specific antibody 19987-1-AP | Download protocol |
| WB protocol for LDHA-Specific antibody 19987-1-AP | Download protocol |
| Standard Protocols | |
|---|---|
| Click here to view our Standard Protocols |
发表文章
| Species | Application | Title |
|---|---|---|
Cell Metab Acetate enables metabolic fitness and cognitive performance during sleep disruption | ||
Nat Cell Biol RIP3 targets pyruvate dehydrogenase complex to increase aerobic respiration in TNF-induced necroptosis | ||
Drug Resist Updat Targeting ACYP1-mediated glycolysis reverses lenvatinib resistance and restricts hepatocellular carcinoma progression
| ||
Cell Stem Cell Region-specific cellular and molecular basis of liver regeneration after acute pericentral injury | ||
Nat Immunol NKILA lncRNA promotes tumor immune evasion by sensitizing T cells to activation-induced cell death. |